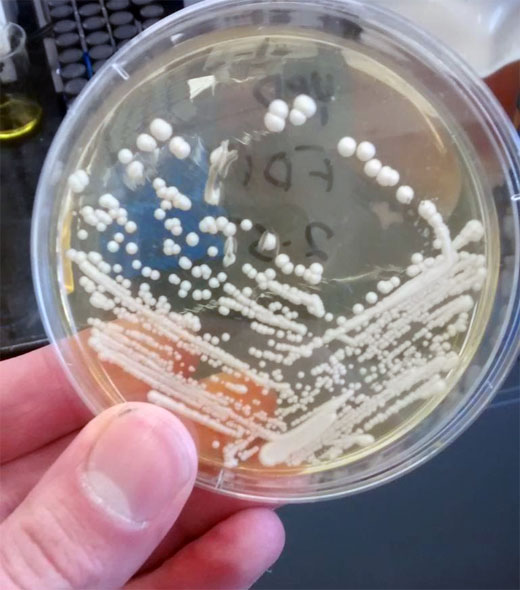

Buenos Aires, Sábado 04 de Abril de 2026
Acerca de EsteticaMedica | Clasificados | Eventos | Actividades | Staff | Publicidad | Contacto

25-02-2025 | Capacitación
En marzo, posgrado en nutrición y medicina orthomolecular
Organizado por Farmacia Milenium, y con la dirección académica del Prof. Dr. Carlos Castells, el 15 de marzo próximo dará comienzo la edición 2025 del Curso Superior de Posgrado en Nutrición Médica y Medicina Orthomolecular. Info y programa.

17-01-2025 | Capacitación
El evento del año: masterclass intensiva de medicina orthomolecular y nutrición
Del 2 al 5 de abril, en Buenos Aires, esta capacitación full inmersion juntará por primera vez a los doctores Efraín Olszewer y Carlos Castells, los profesionales más influyentes de la medicina orthomolecular y la nutrición médica del continente. El programa preliminar.

09-12-2024 | Capacitación
Capacitación online en Sueros
El 22 de febrero se desarrollará el primer taller online de Sueros del año 2025 a cargo del doctor Gabriel Romeu. Este reconocido workshop teórico práctico en nutrición parenteral está basado en tres ejes: formulaciones, experiencia y bases cientificas. El temario.


11-11-2024 | Capacitación
Diciembre: jornada presencial de medicina orthomolecular
Organizada por EIMO Escuela Iberoamericana de Medicina Orthomolecular, el 7 de diciembre la Dra. Alejandra Rodríguez Zía presentará en Buenos Aires "Pensando a tu Paciente". Destinada a médicos, veterinarios y odontólogos, ofrecerá claves de la medicina orthomolecular aplicadas a la clínica para personalizar tratamientos.

21-08-2024 | Capacitación
Temario del CIED 2024
La finalidad de este reconocido curso internacional Hands On es poner al día los conceptos básicos de la Ecografía Doppler aplicados al estudio de la enfermedad venosa crónica y su utilización en la realización de distintos tratamientos endovasculares venosos.
Capacitación | Organiza Biofarma el 3 de septiembre
Curso teórico práctico: Aplicaciones de peptonas en medicina estética
Organizado por Farmacia y Laboratorio Biofarma, se realizará el día 3 de septiembre de 2016 el Curso teórico práctico de Medicina Biológica en Medicina Estética: aplicaciones de peptonas en Medicina Estética. A cargo estará la doctora Giselle V. García Moro.
Martes 17 de Mayo de 2016
El curso se llevará a cabo en el horario de 10 a 17 horas. en el Salón El Galeón del hotel El Conquistador, ubicado Suipacha 948 de la Ciudad de Buenos Aires.
 Dra. Giselle V. García Moro
Dra. Giselle V. García MoroFormación como médica Anti-Age, Ozonoterapia y Quelación. Especialización médica en Clínica Estética en la UBA. Docente del Centro de Investigación en la OEA. Docente de Estética en ACYEBA. Disertante en congresos nacionales y provinciales. Creadora y docente del masaje de drenaje venoso manual de miembros inferiores y superiores. Miembro de la Asociación de ACYEBA. Co-autora del libro de Aromaterapia Científica, publicado en la gacetilla de la Universidad de Staford. Autora del Manual de Técnicas en Flebologia de Drenaje Venoso.
Programa del curso práctico de Medicina Biológica en Medicina Estética
- Rellenos con peptonas que estimulan el neo colágeno tipo 1 estimulando el auto relleno.
- Utilización de peptonas en el campo quirúrgico estimulando la reparación y formación de la neo vascularización.
- Potenciación de la autovacuna con peptonas.
- Regenera, repara, potencia y enriquece la neo vascularización de los tejidos tratados con PRP y peptonas simultánea y paliativamente en el mismo proceso con diferentes técnicas de mesoterapia, relleno, transferencia de tejido graso y en campo quirúrgico.
- Utilización del Dermopen Peptum con peptonas.
- Utilización del Mesoroller Peptum con peptonas.
- Mesoglob Facial Peptum (hidratación, nutrición, tensor, reparador, anti-age) combinado con peptonas.
- Hidratación Peptum del skinbooster de ácido hialurónico con peptonas.
- Potenciar Peptum del skinbooster de ácido hialurónico con peptonas en pieles muy delgadas y/o deshidratación extrema con PCSA.
- Potenciación de las peptonas con ozonoterapia.
- Tratamientos capilares con peptonas combinado con mesoterapia. Intramuscular. Comprimidos. Preparación de shampoo y loción.
- Tratamientos de mesoterapia con peptonas en acné, rosácea, manchas, hirsutismo, dermatitis (atópica, seborreica y alérgica) y piel oleosa con o sin hiperhidrosis.
- Tratamientos de mesoterapia con peptonas en celulitis.
- Tratamientos de mesoterapia con peptonas combinada con meso tradicional en reducción en centímetros y kilos.
- Tratamientos de mesoterapia con peptonas combinada con meso tradicional en flacidez.
- Tratamientos de mesoterapia con ADN, solo y combinado, para distintas patologías.
- Tratamientos de mesoterapia profunda reductora de fosfatidilcolina con peptonas para disminuir efectos adversos y colaterales.
- Tratamientos de mesoterapia sobre vitiligo y psoriasis.

Curso teórico práctico de Medicina Biológica en Medicina Estética:
Aplicaciones de peptonas en Medicina Estética
Docente: Dra. Giselle V. García Moro
Fecha: sábado 3 de septiembre de 2016
Horario: 10.00 a 17.00 hs.
Sede: Hotel “El Conquistador”(Salón El Galeón), Suipacha 948, CABA
Arancel: consultar
Organiza: Biofarma
Inscripciones y más info:
Tel. (011) 5276-8086 / 87 / 88 / 89
eventosbiofarma@hotmail.com
www.farmaciabiofarma.com.ar
Fuente: Farmacia Biofarma
Deje su comentario
IMPORTANTE: Los comentarios publicados son de exclusiva responsabilidad de sus autores y las consecuencias derivadas de ellas pueden ser pasibles de las sanciones legales que correspondan. Aquel usuario que incluya en sus mensajes algun comentario violatorio del reglamento será eliminado e inhabilitado para volver a comentar.
COMENTARIOS DE LOS LECTORES (0)
Capacitación

Temario del CIED 2024
La finalidad de este reconocido curso internacional Hands On es poner al día los conceptos básicos de la Ecografía Doppler aplicados al estudio de la enfermedad venosa crónica y su utilización en la realización de distintos tratamientos endovasculares venosos.

Descubren la influencia de la proteína IL-11 en longevidad y envejecimiento
Publicado en Nature, el sorprendente rol de la IL-11 se descubrió por casualidad. Equipos del Imperial College London y Duke-NUS de Singapur investigaban un método para detectar esta proteína cuando notaron algo inesperado. La clave: su función en la inflamación crónica.

Diciembre: jornada presencial de medicina orthomolecular
Organizada por EIMO Escuela Iberoamericana de Medicina Orthomolecular, el 7 de diciembre la Dra. Alejandra Rodríguez Zía presentará en Buenos Aires "Pensando a tu Paciente". Destinada a médicos, veterinarios y odontólogos, ofrecerá claves de la medicina orthomolecular aplicadas a la clínica para personalizar tratamientos.
- Curso de Medicina Biológica a cargo del doctor Enrique
- Tercer módulo de las Jornadas de Capacitación Científica en Medicina Antienvejecimiento y Regenerativa
- Curso de medicina estética orthomolecular con peptonas
- Segundo módulo de las Jornadas de Capacitación Científica en Medicina Antienvejecimiento y Regenerativa
- El 15 de noviembre Biofarma organiza una jornada de capacitación en terapia biológica
- Farmacia y Laboratorio Biofarma: el desafío de crear la diferencia
- Primer curso de las Jornadas de Capacitación Científica en Medicina Antienvejecimiento y Regenerativa
- Curso del Dr. Miguel Guerrini: Lo nuevo en Medicina Ortomolecular
- Jornada: Estrategias Terapéuticas en Antienvejecimiento
- Terapia Antienvejecimiento de Avanzada: jornada de Regeneración Celular con Células Madre Autólogas
- Curso de nuevas aplicaciones de Medicina Ortomolecular y Biológica en Medicina Estética
- Liquid Beauty, último módulo de las Jornadas Antienvejecimiento
EL QUE BUSCA, ENCUENTRA.
Estetica-medica.info ofrece a todos los profesionales, empresas e instituciones del rubro la oportunidad de publicar gratuitamente en sus Clasificados, que cuenta con 3 tipos de avisos: Trabajo Pedido (búsqueda de personal), Trabajo Ofrecido (profesionales que buscan trabajo) y oportunidades Comerciales (compra/venta particular de equipamiento usado, fondos de comercio, alquiler, permutas, etc.).
Para publicar su aviso, complete, a continuación, el formulario online.
Encuesta
Qué le parece el nuevo sitio de EstéticaMédica.info?
VIDEOVITRINA > EQUIPOS BELLCURVS
Todos los equipos de Bellcurvs Medical & Aesthetic. Venta y alquiler. Más info
------------------------------------------------------------------------------------
Antiaging
La importancia de las vitaminas en la medicina antiaging

Lo que se trata de evitar es el proceso de oxidación prematuro de las células y, por consiguiente, su mal funcionamiento por carencias de ciertas vitaminas imprescindibles para el buen funcionamiento del medio interno. Su correcta reposición conlleva una buena evaluación médica personalizada.
Revitalización biológica y celuloterapia ortomolecular

Envejecer es sinónimo de desvitalización. En cambio, la terapia biológica celular equivale a revitalizar. Es una verdadera revitalización celular. Todos los órganos de nuestro cuerpo pueden ser revitalizados con una terapia específica. El principio básico de la terapia celular es la órgano-especificidad: la piel cura a la piel, el hígado cura al hígado y así será para cada órgano o tejido tratado.
Células madre: pilar básico del proceso de renovación celular

Se multiplican mediante divisiones mitóticas para dar lugar a otras células madre idénticas. También tienen la capacidad de diferenciarse en diversos tipos de células especializadas. En tecnología cosmética hace referencia principalmente a activos de origen vegetal capaces de activar el metabolismo celular.
Neuroplasticidad, nootrópicos y regeneración neuronal

Proceso continuo que modifica las redes neuronales existentes haciendo adaptaciones estructurales y funcionales en las sinapsis, la neuroplasticidad actúa como respuesta a los cambios en el comportamiento. En otras palabras, un “recableado” del circuito neuronal cada vez que se aprende algo nuevo.
Terapia de Reemplazo Hormonal Bioidéntica, TRHB

Lo primero que hay que hacer es medir hormonas para ver en qué niveles se encuentran. Una vez que se decide qué hay que suplementar, se determina la dosis y modo de administración y se le explica al paciente; después la idea es chequear los niveles hormonales a los dos meses. El tratamiento suele extenderse por tres años en mujeres con premenopausia.
El rol del gen Sirt1 en el proceso de envejecimiento

Los telómeros se acortan de forma natural con la edad, pero las conductas poco saludables pueden hacer que se acorten antes, inactivando el gen Sirt1 y acelerando los procesos de envejecimiento. La buena noticia es que científicos demostraron que es posible volver a activarlo.